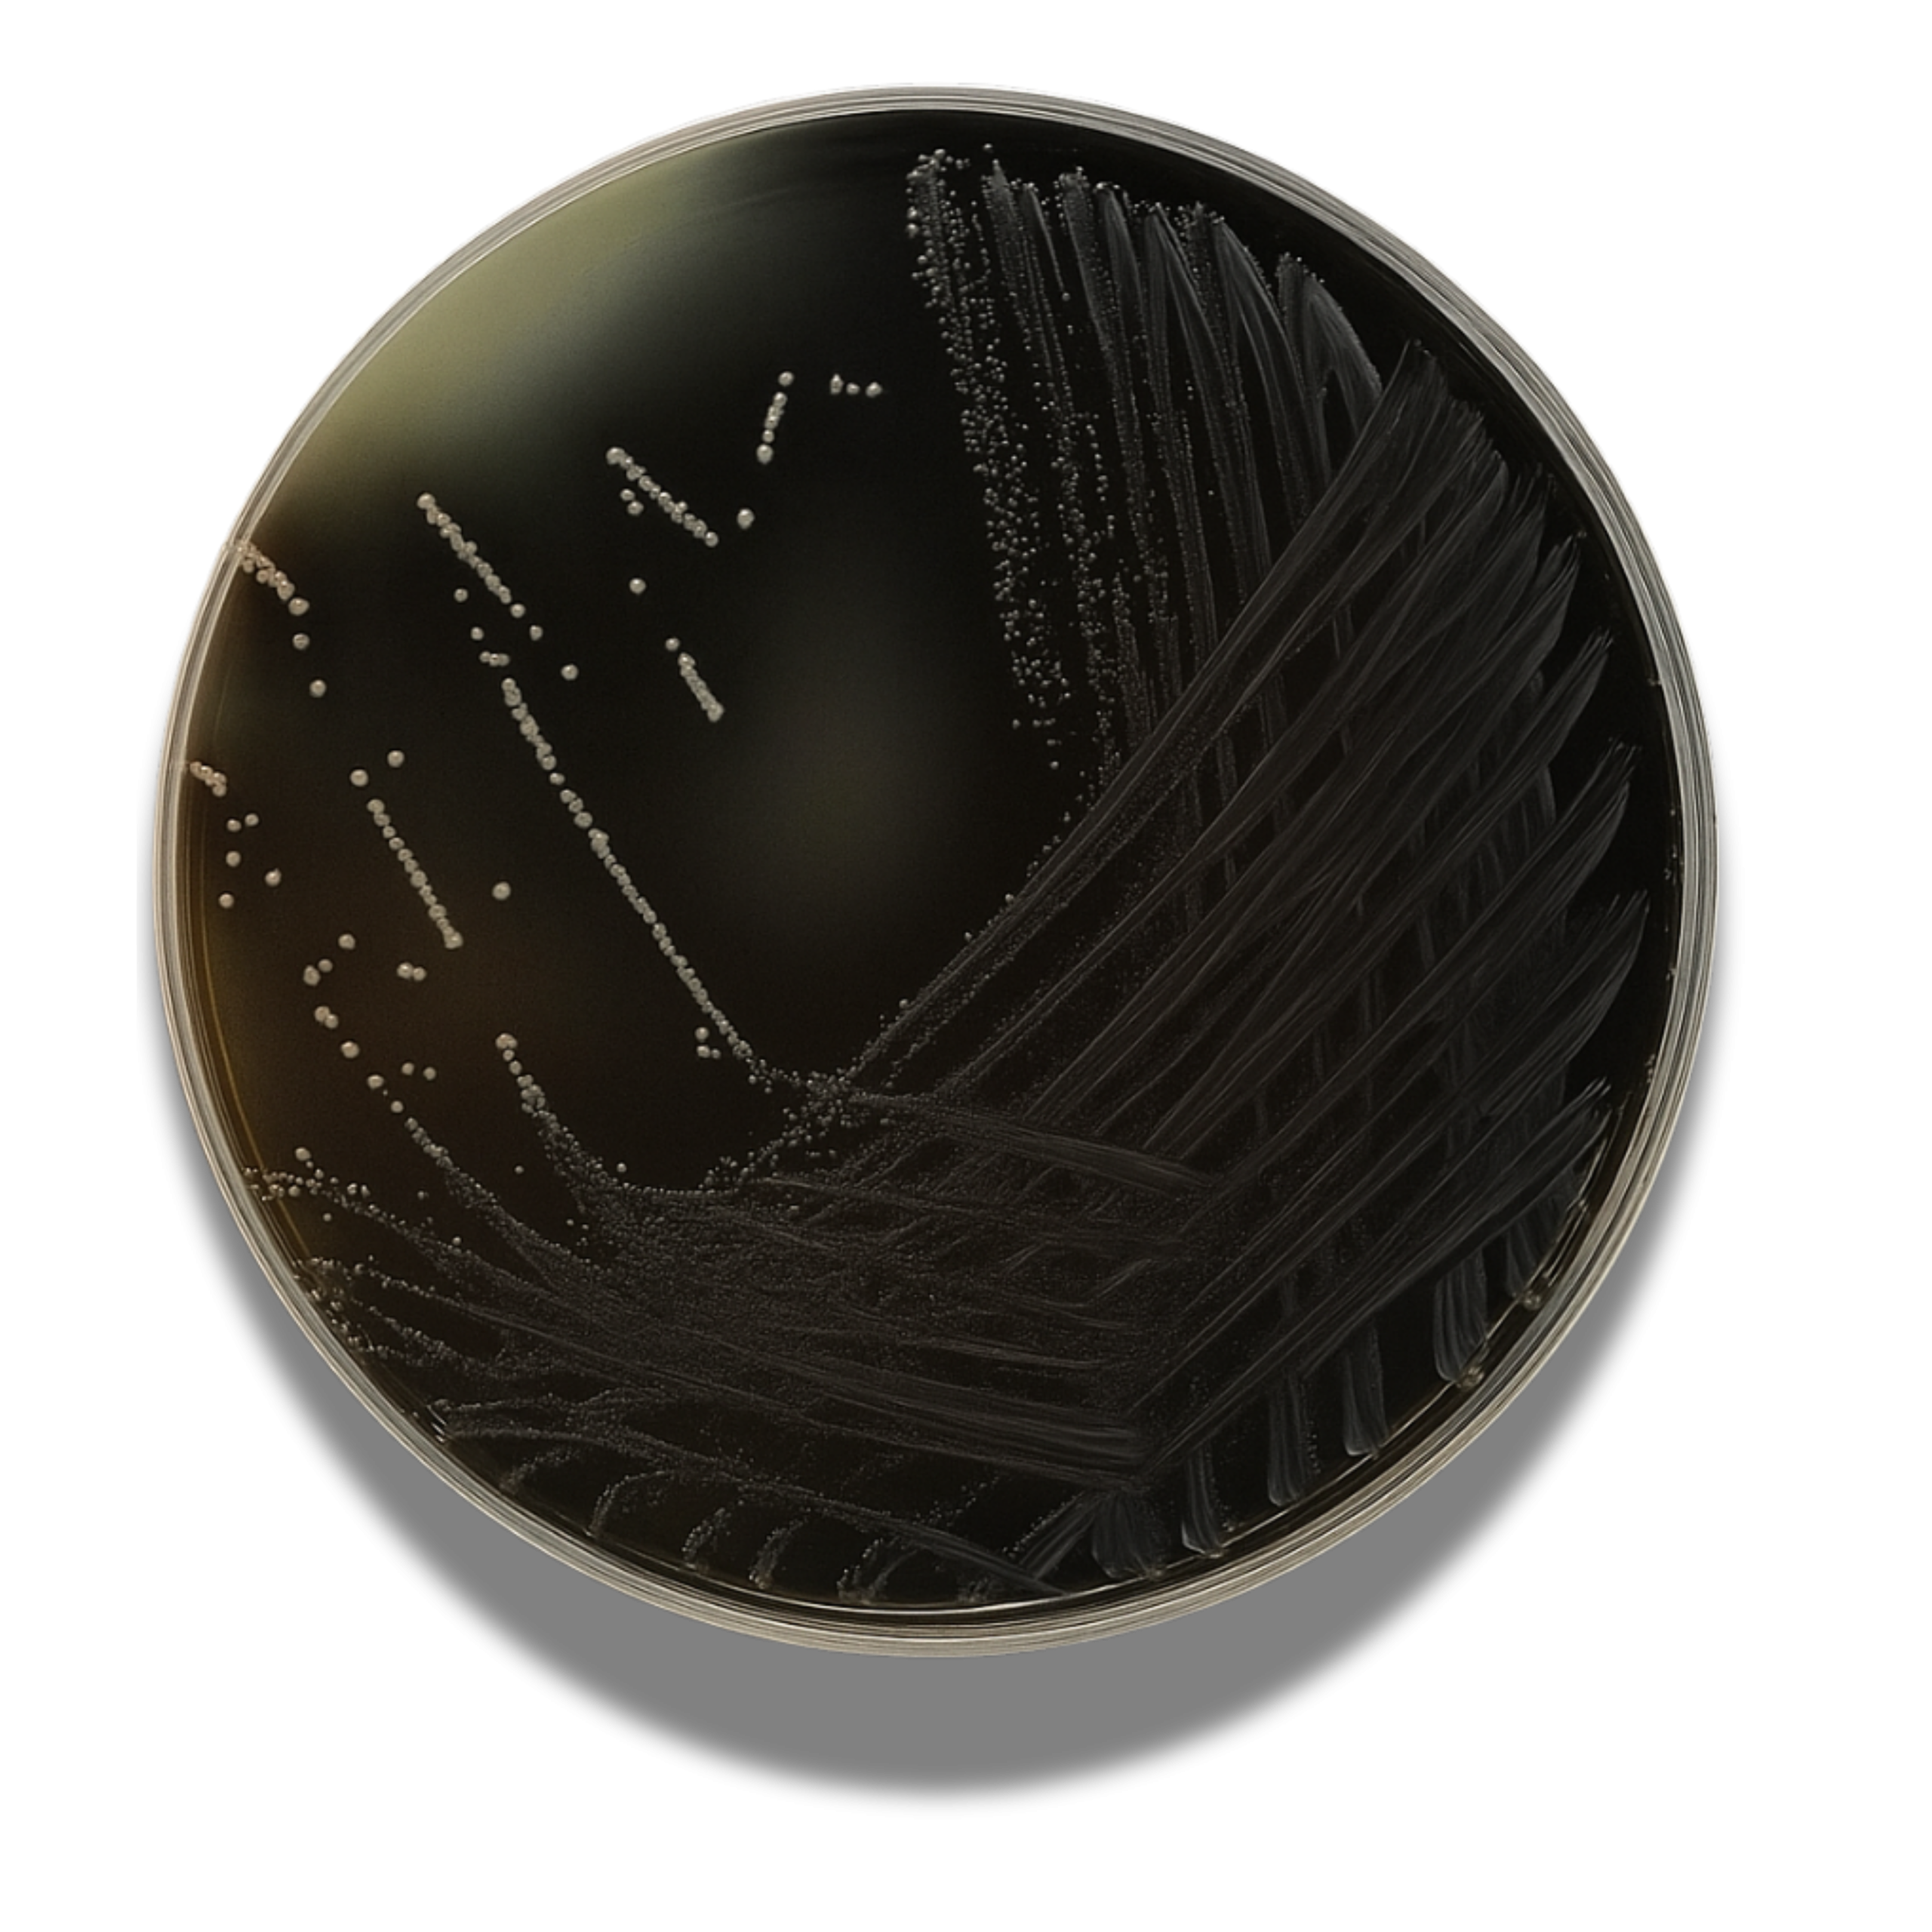

- Wishlist
- SKU : 4010142
- AESCULIN BILE AZIDE AGAR
Additional Info
| Brand |
BioLife |
|---|---|
| Unit |
500 Grams |
Selective and differential medium for the isolation and differentiation of enterococci from food, water and environmental samples.
Be the first to review “AESCULIN BILE AZIDE AGAR” Cancel reply
You must be logged in to post a review.
Reviews
There are no reviews yet.